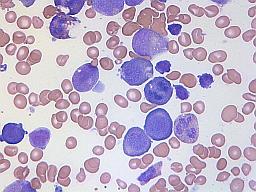
Image

Megaloblastäre Anämien
Bei den megaloblastären Anämien liegen Entwicklungs- und Reifungsstörungen der roten Blutkörperchen im Knochenmark vor. Man findet dort ungewöhnlich große und nicht normal funktionierende rote Blutzellen mit unreifen Zellkernen vor, den sogenannten Megaloblasten.
Autor: Dr. med. habil. Gesche Tallen, Redaktion: Ingrid Grüneberg, Freigabe: PD Dr. med. J. Kunz, Prof. Dr. med. U. Creutzig, Zuletzt geändert: 08.09.2025 https://kinderblutkrankheiten.de/doi/e224514
Bei den megaloblastären Anämien handelt es sich um bestimmte Formen der Blutarmut (Anämie), die insgesamt bei Kindern und Jugendlichen selten vorkommen. Diese Arten von Anämien entstehen, wenn das Knochenmark ungewöhnlich große und nicht normal funktionierende rote Blutzellen mit übergroßen, unreifen Zellkernen, so genannte Megaloblasten, produziert. Oft ist dabei nicht nur die Bildung der roten Blutkörperchen, sondern auch die der weißen Blutkörperchen und der Blutplättchen gestört.
Aufgrund ihrer abnormalen Größe und Struktur können die Megaloblasten das Knochenmark nicht wie üblich verlassen. In der Folge kommt es zum Mangel an roten Blutzellen im Organismus und damit bei den Patienten zu typischen Beschwerden einer Anämie wie Abgeschlagenheit, Kopfschmerzen, Blässe, Kurzatmigkeit, häufiges Herzrasen und Schwindel. Manche Patienten klagen zusätzlich über Bauchschmerzen, Kribbelgefühle in Händen und/oder Füßen, Seh-, Konzentrations- und Gedächtnisstörungen.
Megaloblastäre Anämien können verschiedene Ursachen haben – zu den beiden häufigsten zählen der Vitamin B9 (Folat)-Mangel und der Vitamin B12 (Kobalamin)-Mangel. Diese Vitamine sind wesentlich an der Produktion gesunder roter Blutzellen beteiligt.
Der folgende Informationstext richtet sich an Patienten mit megaloblastären Anämien, wie an deren Angehörige, Freunde, Lehrer und andere Bezugspersonen sowie an die interessierte Öffentlichkeit. Er soll dazu beitragen, eine solche Erkrankung frühzeitig zu erkennen und die Möglichkeiten ihrer Behandlung sowie die Probleme und besonderen Bedürfnisse der Patienten besser zu begreifen. Unsere Informationen ersetzen nicht die erforderlichen klärenden Gespräche mit den behandelnden Ärzten und weiteren Mitarbeitern des Behandlungsteams; sie können aber dabei behilflich sein, diese Gespräche vorzubereiten und besser zu verstehen.
Anmerkungen zum Text
Die in diesem Patiententext enthaltenen Informationen sind von den oben genannten Autoren erstellt worden. Diese Autoren sind Spezialisten für Blutkrankheiten bei Kindern und Jugendlichen. Der Informationstext basiert auf den Erfahrungen der Spezialisten und auf der unten angegebenen Literatur. Der Text wurde durch die oben angegebenen Redakteure zuletzt im Februar 2021 für dieses Informationsportal bearbeitet und zur Einstellung ins Internet für die Dauer von fünf Jahren freigegeben. Er soll spätestens nach Ablauf dieser Frist erneut überprüft und aktualisiert werden.
Bitte beachten Sie, dass es sich im Folgenden um allgemeine Informationen und Empfehlungen handelt, die – aus der komplexen Situation heraus – nicht notwendigerweise in ihrer Gesamtheit bei jedem Patienten zutreffen. Viele Therapieempfehlungen müssen im Einzelfall und im Team entschieden werden. Ihr Behandlungsteam wird Sie über die für Ihr Kind am ehesten in Frage kommenden Maßnahmen informieren.
Basisliteratur 
- Hariz A, Priyanka T, Bhattacharya PT: Megaloblastic Anemia. In: StatPearls [Internet]. Treasure Island (FL) StatPearls Publishing; 2020 [URI: https://pubmed.ncbi.nlm.nih.gov/ 30725939/ ]
- Wolffenbuttel BHR, Wouters HJCM, Heiner-Fokkema MR, van der Klauw MM: The Many Faces of Cobalamin (Vitamin B12) Deficiency. Mayo Clinic proceedings. Innovations, quality & outcomes 2019, 3: 200 [PMID: 31193945]
- Kunz J, Kulozik A: Makrozytäre Anämien. In: Niemeyer C, Eggert A. ed. Pädiatrische Hämatologie und Onkologie Springer; 2018 54
- Mahmood L: The metabolic processes of folic acid and Vitamin B12 deficiency. J Health Res Rev 2014, 1: 5 - 9
- Lerner LB: Megaloblastic Anemias. In: Nelson Textbook of Pediatrics, 19th Edition - ed. by Kliegman RM, St. Geme J 2011, 448: 1655
- Whitehead VM: Acquired and inherited disorders of cobalamin and folate in children. British journal of haematology 2006, 134: 125 [PMID: 16846473]

Patienteninformation zu den megaloblastären Anämien (337KB)